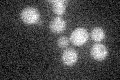
YIL087C
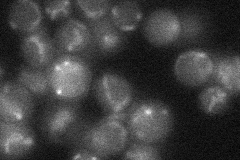
YIL087C
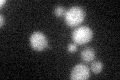
YIL087C

View description
Putative protein of unknown function; the authentic, non-tagged protein is detected in purified mitochondria in high-throughput studies; null mutant displays reduced respiratory growth
Localization:
Intensity:
Fold change:
Significance:
-
C’ GFP library in SD
mitochondria17.77 -
N' NOP1pr-GFP in SD

mitochondria88.5462 -
N' TEF2pr-mCherry in SD

mitochondria15.2787 -
N' NATIVEpr-GFP in SD
mitochondria25.8284 -
N' TEF2pr-VC and Cyto-VN in SD

mitochondria29.1314 -
C’ GFP library in SD+DTT
mitochondria16.710.94No -
C’ GFP library in SD+H2O2

mitochondria17.630.99No -
C’ GFP library in Starvation Media

mitochondria17.450.98No -
C’ GFP library on the background of Pup2-DaMP

mitochondria -
C’ GFP library on the background of CCT mutant

mitochondria17.1110.962537No
